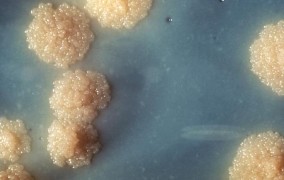

Notícias
-
Pesquisadores identificam ‘enrijecimento do tipo Higgs’ em transições de fase
24 de junho de 2026Mecanismo análogo ao de criação de massa emerge na vizinhança de transições de fase; o estudo também aponta conexões do fenômeno com as chamadas excitações fractônicas, que vêm ganhando destaque na física de sistemas fortemente correlacionados -
Atividade física ao longo da vida reduz risco de depressão na velhice
24 de junho de 2026Estudo que analisou dados de mais de 15 mil pessoas na meia-idade mostra que exercícios moderados, mesmo em baixa frequência, já oferecem proteção à saúde mental -
FAPESP lança nova chamada do PROASA
24 de junho de 2026Fundação destinará R$ 15 milhões para projetos de pesquisa voltados ao Oceano Atlântico Sul e à Antártida -
Cientistas propõem medidas para conter avanço de fungos resistentes a medicamentos
23 de junho de 2026Estudo publicado na Nature Medicine destaca que o uso indiscriminado de fungicidas na agricultura e na medicina veterinária compromete tratamentos humanos e defende olhar integrado para conter a crise -
Estudo descreve avanço explosivo da febre amarela em fragmento florestal da cidade de São Paulo
23 de junho de 2026Trabalho publicado na Nature Microbiology reconstituiu o surto ocorrido na Região Metropolitana entre 2017 e 2018. Dados mostram nível de transmissão muito elevado e uma dinâmica diferente da observada em outras regiões do país -
FAPESP promove chamada com o Fundo para o Desenvolvimento da Ciência e da Tecnologia de Macau
23 de junho de 2026Serão apoiadas pesquisas colaborativas em 11 áreas que contemplam os eixos estratégicos de pesquisa que estruturam a atuação da Fundação no triênio 2026-28 -
Tecnologia baseada em fibras sintéticas recicladas permite produzir água potável a partir da umidade do ar
22 de junho de 2026Pesquisadores desenvolveram sistema capaz de gerar até 6 litros de água por dia usando células de um material oriundo do reaproveitamento de resíduos têxteis -
Homens idosos que dormem mais de nove horas têm maior risco de perder mobilidade
22 de junho de 2026Estudo acompanhou mais de 3 mil pessoas acima dos 60 ao longo de oito anos e apontou que o mesmo declínio não é observado nas mulheres -
Ciência de dados a favor do SUS é tema da série Conferências FAPESP 2026
22 de junho de 2026Manoel Barral-Netto, da Fiocruz-Bahia, falará sobre como dados administrativos podem ser transformados em evidências robustas para orientar políticas públicas e decisões em saúde -
Crescimento desordenado das cidades paulistas impacta o ambiente e a produtividade econômica
19 de junho de 2026Fenômeno conhecido como “espraiamento urbano” foi debatido em workshop na USP; grupo desenvolve ferramentas para orientar o planejamento sustentável dos municípios até 2040 -
Fungo patogênico transmitido pelo arranhão do gato doméstico está presente em animais selvagens
19 de junho de 2026Pesquisadores detectaram espécies patogênicas de Sporothrix nos órgãos internos de mamíferos, aves e répteis atropelados em estradas do Paraná; estudo revela novo reservatório para fungos e alerta para necessidade de vigilância -
Podcast promove reflexão crítica sobre ciência, política científica e a vida acadêmica no Brasil
19 de junho de 2026“Para além do Lattes”, produção de Daniel Martins-de-Souza, professor da Unicamp, aborda diferentes dimensões da trajetória profissional em universidades e institutos de pesquisa -
Terapia celular CAR-T será testada no tratamento de doenças autoimunes
18 de junho de 2026Parceria entre FAPESP, Instituto Butantan, Hemocentro de Ribeirão Preto e USP prevê a realização de ensaios clínicos envolvendo pacientes com lúpus eritematoso sistêmico e miastenia gravis generalizada -
FAPESP cria bolsa de Inovação Tecnológica para estudantes das Fatecs
18 de junho de 2026Com edital inicial de R$ 20 milhões, programa vai oferecer até mil bolsas para projetos focados em solucionar desafios reais de setores como indústria, agronegócio e saúde -
Sedimentos da costa do Maranhão registram alterações bruscas no transporte de calor do Atlântico
18 de junho de 2026Pesquisa mostra que o sistema fundamental para o clima da Terra, conhecido como AMOC, já passou por mudanças repentinas no passado, impulsionadas por alterações climáticas como as que estamos vivenciando agora -
Projeto GMT Brasil lança série de vídeos curtos sobre astronomia
18 de junho de 2026Com foco no público jovem, o escritório brasileiro do Telescópio Gigante Magalhães aposta no formato shorts para explorar a história visual do Sistema Solar -
Fotônica quântica e não linear é tema de Escola São Paulo de Ciência Avançada
17 de junho de 2026Evento ocorrerá entre os dias 16 e 27 de novembro, em Campinas; inscrições até 30 de junho -
Aplicativo de startup apoiada pelo PIPE é premiado pela Embratur
17 de junho de 2026Desenvolvido pela Fubá Educação Ambiental, o app BoRa busca promover o turismo sustentável e a educação ambiental -
Novo centro vai avaliar impacto da música na saúde mental de jovens e adolescentes
16 de junho de 2026Sediado na capital paulista, o Centro Interdisciplinar para o Desenvolvimento da Pesquisa em Música é uma parceria entre FAPESP, Unesp e Secretaria da Cultura, Economia e Indústria Criativas -
Nova técnica identifica estrelas que engoliram planetas
16 de junho de 2026Pesquisa internacional liderada por equipe da USP sugere que sistemas estáveis – como o Sistema Solar – talvez sejam menos comuns do que se imaginava, o que impacta o surgimento de vida complexa -
Instituto Butantan e Science Museum de Londres planejam exposição conjunta sobre a dengue
16 de junho de 2026Anunciada na FAPESP Week Londres, iniciativa abordará a expansão global da doença sob diferentes aspectos, como social, climático e geopolítico -
O cientista brasileiro que liderou a digitalização de 400 anos de história da flora do planeta
16 de junho de 2026Alexandre Antonelli, primeiro pesquisador do país a liderar a área científica do Kew Gardens de Londres, detalha à Agência FAPESP como foi o esforço de escanear 6,4 milhões de espécimes de plantas e revela que o megaprojeto britânico foi inspirado em uma iniciativa brasileira -
FAPESP busca cooperação com Inserm para pesquisas em doenças cardiovasculares e diabetes
16 de junho de 2026Em reunião com delegação do Instituto Nacional de Pesquisa Médica e de Saúde da França, foi assinado memorando de entendimento nas áreas de ciências da vida e da saúde -
Substância do alho aumenta a eficácia de quimioterapia contra o câncer colorretal
16 de junho de 2026Estudo em modelos celulares demonstrou ação do dissulfeto de dialila em combinação com um medicamento comumente usado no combate à doença -
Pesquisa identifica nova mutação relacionada ao câncer de pulmão
15 de junho de 2026Trabalho analisou amostras tumorais de mais de mil pacientes atendidos pelo SUS e verificou que mutações no gene TP53 afetam resposta à terapia -
Estudo detalha como o organismo se adapta a dietas com muita proteína e nenhum carboidrato
15 de junho de 2026Em experimento com roedores, grupo da USP identificou as proteínas que assumem o controle do fígado para garantir a produção contínua de glicose mesmo durante o jejum -
Chamada em educação infantil na pré-escola tem prazo prorrogado até 22 de junho
15 de junho de 2026Iniciativa da FAPESP e das fundações Bracell e Itaú visa aproximar a pesquisa acadêmica da prática educacional e da formulação de políticas públicas -
Impacto do aquecimento global na reprodução dos peixes pode ser temporário
12 de junho de 2026Experimento de dez anos feito com robalo-europeu revela que a superpopulação de machos causada pela água quente é revertida pelo nascimento de mais fêmeas na terceira geração -
Inscrições para a 5ª edição do Prêmio Ciência para Todos são prorrogadas até 21/06
12 de junho de 2026Tema de iniciativa da FAPESP em parceria com a Fundação Roberto Marinho é o papel da ciência na construção de soluções criativas para desafios locais -
Sensores biodegradáveis acoplados em plantas detectam pesticidas em três minutos
12 de junho de 2026Confeccionados com material atóxico de origem vegetal, dispositivos podem monitorar também biomarcadores, doenças e níveis de nutrientes nas plantas -
Corpo aproveita pouco os minerais das castanhas, diz estudo que simulou a digestão humana
11 de junho de 2026Experimento feito na Unifesp mostra que o organismo consegue liberar apenas uma fração do cobre e do magnésio presentes na castanha-de-caju e na castanha-do-pará -
São Paulo terá a primeira usina do país para capturar e armazenar carbono do etanol de cana
11 de junho de 2026Iniciativa com investimento estimado de R$ 30 milhões reúne FAPESP, USP, Secretaria de Estado do Meio Ambiente e setor produtivo -
Presidente do Telescópio Gigante Magalhães busca novos recursos para finalizar o projeto
11 de junho de 2026Em entrevista à Agência FAPESP, Daniel T. Jaffe falou sobre o andamento das obras do megatelescópio no Atacama e a expectativa para a aprovação de financiamento bilionário pelo Congresso norte-americano -
Jovens LGBTQIAPN+ apresentam maior risco de uso de substâncias psicoativas
10 de junho de 2026Pesquisa da USP avaliou dados de 1.492 pessoas sobre consumo de álcool, tabaco, cannabis e cocaína; resultados sugerem a influência de fatores como discriminação, estigma e exclusão social como causas do comportamento -
FAPESP lança nova chamada com o European Research Council
10 de junho de 2026Serão apoiadas colaborações de pesquisadores do Estado de São Paulo com cientistas europeus -
Pesquisa contesta suposto efeito anti-inflamatório da creatina
10 de junho de 2026Revisão de estudos clínicos realizada por pesquisadores da Unesp confirmou a segurança do produto, mas não encontrou efeitos significativos sobre marcadores inflamatórios no organismo -
Passado agrícola da Amazônia revela segredos sobre a resiliência da floresta
09 de junho de 2026Estudo apresentado na FAPESP Week Londres utiliza sequenciamento genético de castanheiras-do-pará para entender como ecossistemas se recuperam após milênios de manejo humano -
Projeto vai oferecer teste genético gratuito para casais que planejam ter filhos
09 de junho de 2026Iniciativa apoiada pela FAPESP visa mapear genes associados a doenças hereditárias raras para criar “calculadoras de risco”, baseadas na diversidade da população brasileira -
Farinha de alga marrom eleva valor nutritivo e digestibilidade de biscoitos sem glúten
09 de junho de 2026Ingrediente proveniente da espécie Sargassum filipendula apresenta alto potencial como componente funcional mesmo em pequenas quantidades -
Tecnologia usada no Coliseu de Roma vai monitorar conservação do Museu do Ipiranga
08 de junho de 2026Escaneamento a laser 3D permitirá criar modelo digital do edifício reformado e estabelecer sistema de gestão da informação para manutenção preventiva; projeto foi apresentado durante a FAPESP Week Londres -
Relógio inteligente detecta ansiedade e estresse em tempo real
08 de junho de 2026Tecnologia experimental desenvolvida em Centro de Pesquisa Aplicada da Unicamp já acerta mais de 80% das análises; trabalho foi apresentado durante a FAPESP Week Londres -
Inscrições para o Prêmio Ciência para Todos vão até sexta-feira (12/06)
08 de junho de 2026Em sua 5ª edição, iniciativa convida a refletir sobre o papel da ciência na construção de soluções criativas para os desafios locais -
FAPESP e Reino Unido abrem nova fase de cooperação científica em Londres
03 de junho de 2026Na abertura da FAPESP Week, participantes celebram o impacto da cooperação bilateral e apontam inteligência artificial e biotecnologia como áreas prioritárias para o futuro -
Brasil precisa superar gargalos ambientais e tecnológicos para viabilizar mineração de terras-raras
03 de junho de 2026Durante a FAPESP Week Londres, o especialista Fernando Landgraf apontou que, para além do potencial mineral, país deve dominar etapas de refino e produção de insumos disputados globalmente por Estados Unidos e China -
Nanotecnologia brasileira permite tratar doenças de pele com precisão
03 de junho de 2026Grupo da USP produz nanopartículas de cristal líquido com moléculas terapêuticas para reduzir inflamação em doenças como psoríase e vitiligo; avanços foram apresentados na FAPESP Week Londres -
Parceria científica entre Brasil e Argentina resiste a crises e fragmentação geopolítica
02 de junho de 2026Durante a 3ª Conferência FAPESP 2026, Ernesto Mané Jr., chefe do Setor de Ciência, Tecnologia e Inovação da Embaixada do Brasil em Buenos Aires, aponta caminhos para manter ativa a colaboração entre os países -
Combinação de metais abundantes pode baratear produção de hidrogênio verde
02 de junho de 2026Pesquisadores brasileiros usam supercomputadores para prever misturas ideais de elementos comuns, como ferro e níquel, e criar catalisadores de baixo custo capazes de substituir materiais nobres e caros como a platina -
Inteligência artificial converte câmeras de segurança em sistemas de monitoramento ativo
02 de junho de 2026Tecnologia de aprendizado autônomo desenvolvida por startup apoiada pelo PIPE-FAPESP filtra imagens irrelevantes e reduz falhas humanas na vigilância -
Pesquisadoras descobrem nova espécie de microrganismo adaptado a frio e calor extremos na Antártida
01 de junho de 2026A Pyroantarticum pellizari vive em uma ilha vulcânica do continente gelado; descoberta é uma peça no quebra-cabeças da evolução das arqueias, domínio relativamente pouco explorado da vida terrestre -
FAPESP busca impulsionar colaboração científica entre São Paulo e o Reino Unido
01 de junho de 2026Fundação promove pela terceira vez na Inglaterra o simpósio FAPESP Week, com o objetivo de consolidar e ampliar parcerias em áreas estratégicas como transição energética e inteligência artificial
Mais lidas do mês
-
Fungo patogênico transmitido pelo arranhão do gato doméstico está presente em animais selvagens
19 de junho de 2026
-
Corpo aproveita pouco os minerais das castanhas, diz estudo que simulou a digestão humana
11 de junho de 2026
-
Homens idosos que dormem mais de nove horas têm maior risco de perder mobilidade
22 de junho de 2026
-
São Paulo terá a primeira usina do país para capturar e armazenar carbono do etanol de cana
11 de junho de 2026
-
Relógio inteligente detecta ansiedade e estresse em tempo real
08 de junho de 2026
-
O cientista brasileiro que liderou a digitalização de 400 anos de história da flora do planeta
16 de junho de 2026
-
Pesquisadoras descobrem nova espécie de microrganismo adaptado a frio e calor extremos na Antártida
01 de junho de 2026
-
Estudo detalha como o organismo se adapta a dietas com muita proteína e nenhum carboidrato
15 de junho de 2026
-
Nova técnica identifica estrelas que engoliram planetas
16 de junho de 2026
-
Projeto vai oferecer teste genético gratuito para casais que planejam ter filhos
09 de junho de 2026